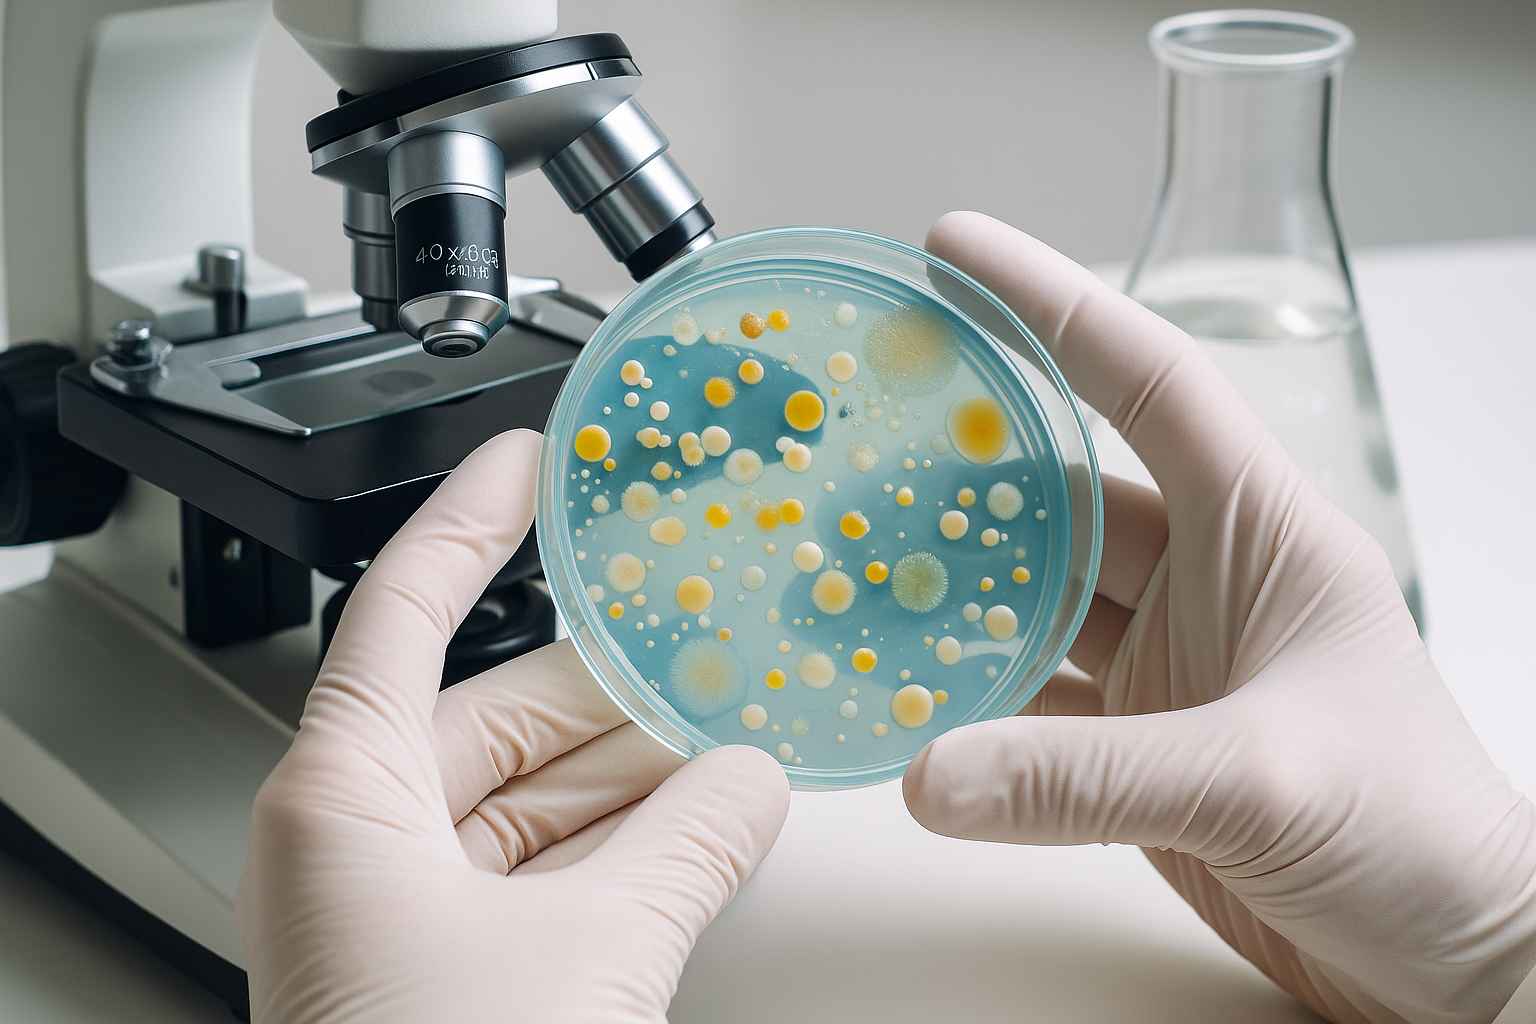

D4TLM.Umsida.ac.id-Kualitas air yang baik adalah fondasi utama bagi kesehatan masyarakat. Meskipun air adalah kebutuhan dasar, masih banyak wilayah di Indonesia yang menghadapi masalah kualitas air yang tidak terjamin.
Baca Juga: HBOT Inovasi FIKES Umsida Turunkan Gula Darah dan Perbaiki Kolesterol
Dalam upaya meningkatkan kualitas air minum yang aman, penting untuk memberikan edukasi kepada masyarakat, khususnya siswa di sekolah-sekolah kejuruan yang nantinya akan terjun ke dunia kesehatan.
Salah satu langkah konkret yang dilakukan oleh Tim Pengabdian Masyarakat Umsida adalah memberikan pelatihan pemeriksaan mikrobiologi air minum di SMK Muhammadiyah 1 Pandaan.
Kegiatan ini bertujuan untuk membekali siswa dengan keterampilan yang dapat digunakan untuk mengatasi masalah kualitas air yang dapat membahayakan kesehatan masyarakat.
Pentingnya Kualitas Air Bagi Kesehatan Masyarakat

Air adalah kebutuhan dasar manusia yang tidak bisa tergantikan. Oleh karena itu, kualitas air minum yang kita konsumsi harus benar-benar terjaga agar tidak menimbulkan masalah kesehatan.
Dalam kehidupan sehari-hari, kita sering kali mengandalkan air dari berbagai sumber, baik itu air minum kemasan, air dari depot air isi ulang, atau air yang diambil dari sumber alami.
Namun, kualitas air dari sumber-sumber tersebut tidak selalu terjamin, terutama terkait dengan kandungan mikroba berbahaya yang dapat menyebabkan penyakit.
Pemeriksaan kualitas air minum menjadi hal yang sangat penting, terutama untuk mengetahui apakah air tersebut mengandung bakteri patogen yang berbahaya bagi tubuh.
Beberapa bakteri yang sering dijadikan indikator kualitas air adalah Escherichia coli dan coliform. Jika kedua bakteri ini ditemukan dalam air minum, maka air tersebut dianggap tidak layak untuk dikonsumsi.
Di Indonesia, meskipun banyak masyarakat yang mengandalkan air minum kemasan atau depot air isi ulang, sering kali kita tidak mengetahui dengan pasti kualitas air tersebut.
Oleh karena itu, penting bagi masyarakat, khususnya para pelajar di sekolah-sekolah kejuruan, untuk memahami cara melakukan pemeriksaan kualitas air minum secara mikrobiologi.
Hal inilah yang mendorong tim Pengabdian Masyarakat Umsida untuk memberikan pelatihan pemeriksaan mikrobiologi air di SMK Muhammadiyah 1 Pandaan.
Program Pelatihan Pemeriksaan Mikrobiologi Air di SMK Muhammadiyah 1 Pandaan
Pada bulan Juli hingga Agustus 2024, Tim Pengabdian Masyarakat dari Program Studi Teknologi Laboratorium Medis (TLM) Umsida bekerja sama dengan SMK Muhammadiyah 1 Pandaan untuk mengadakan pelatihan pemeriksaan mikrobiologi air minum.
Pelatihan ini diikuti oleh 53 siswa dari kelas X, XI, dan XII. “Kami berharap pelatihan ini bisa memberikan pemahaman lebih mendalam kepada siswa tentang pentingnya kualitas air minum dan bagaimana cara memeriksanya secara mikrobiologi,” ujar Miftahul Mushlih, salah satu pengabdi dari Umsida.
Pelatihan dimulai dengan memberikan penjelasan mengenai kualitas air minum, jenis bakteri yang menjadi indikator kualitas air, dan pentingnya pemeriksaan mikrobiologi untuk memastikan air tersebut aman dikonsumsi.
Selain teori, pelatihan ini juga mencakup sesi praktik di laboratorium mikrobiologi, di mana siswa diajarkan cara melakukan pemeriksaan sampel air minum dengan menggunakan teknik yang tepat.
“Pelatihan ini sangat bermanfaat karena memberikan keterampilan yang berguna bagi kami di masa depan. Selain itu, kami juga belajar banyak tentang jenis-jenis bakteri yang bisa ada dalam air dan bagaimana cara mendeteksinya,” kata salah satu siswa peserta pelatihan.
Sesi pelatihan ini tidak hanya dilakukan dengan ceramah dan demonstrasi, tetapi juga dengan pendampingan langsung kepada siswa selama mereka mempraktikkan teknik pemeriksaan air minum.
Kegiatan ini juga diakhiri dengan sesi tanya jawab yang memungkinkan siswa untuk bertanya tentang hal-hal yang belum dipahami.
Dampak Pelatihan terhadap Pemahaman Siswa dan Masyarakat
Pelatihan pemeriksaan mikrobiologi air minum di SMK Muhammadiyah 1 Pandaan diakhiri dengan evaluasi untuk mengukur tingkat pemahaman siswa.
Hasil evaluasi menunjukkan adanya peningkatan yang signifikan dalam pemahaman siswa terkait pemeriksaan mikrobiologi air minum. Sebelum pelatihan, hanya sekitar 24,5% siswa yang memahami materi ini dengan baik, namun setelah pelatihan, angka tersebut meningkat menjadi 90,5%.
“Kami merasa sangat terbantu dengan adanya pelatihan ini. Tidak hanya memberi pengetahuan baru, tapi juga keterampilan yang bisa langsung kami gunakan ketika bekerja nanti,” ujar salah satu peserta pelatihan.
Pelatihan ini juga memberikan dampak positif bagi masyarakat sekitar, terutama terkait kesadaran akan pentingnya menjaga kualitas air minum.
Dengan pemahaman yang lebih baik tentang pemeriksaan mikrobiologi air, siswa dapat berbagi pengetahuan ini dengan keluarga dan teman-temannya, serta mengedukasi masyarakat sekitar tentang pentingnya memeriksa kualitas air sebelum dikonsumsi.
Selain itu, kegiatan ini juga memperlihatkan betapa pentingnya kolaborasi antara institusi pendidikan dan masyarakat. Melalui pengabdian masyarakat ini, UMSIDA telah memberikan kontribusi nyata dalam meningkatkan kesadaran akan pentingnya kualitas air minum di Indonesia.
Pelatihan pemeriksaan mikrobiologi air minum yang dilakukan oleh Tim Pengabdian Masyarakat Umsida di SMK Muhammadiyah 1 Pandaan telah memberikan dampak yang signifikan terhadap pemahaman siswa mengenai kualitas air dan pentingnya pemeriksaan mikrobiologi.
Keterampilan yang didapatkan oleh siswa ini diharapkan dapat digunakan di masa depan untuk menjaga kesehatan masyarakat, baik di lingkungan sekitar mereka maupun dalam dunia kerja.
Pelatihan ini juga membuktikan bahwa edukasi kesehatan masyarakat, terutama terkait dengan kualitas air, sangat penting untuk menciptakan lingkungan yang sehat.
Dengan meningkatkan pengetahuan dan keterampilan tentang pemeriksaan mikrobiologi air minum, masyarakat dapat lebih sadar akan pentingnya menjaga kualitas air yang mereka konsumsi.
Baca Juga: Gaya Hidup Sehat Remaja Investasi Utama Cegah Penyakit Degeneratif
Kegiatan ini juga menunjukkan bahwa pendidikan kejuruan tidak hanya mempersiapkan siswa dengan keterampilan teknis, tetapi juga dengan pengetahuan yang dapat bermanfaat bagi masyarakat secara luas.
Pelatihan ini diharapkan dapat menjadi model bagi sekolah-sekolah kejuruan lainnya, yang dapat mengintegrasikan materi terkait kualitas air minum dan pemeriksaan mikrobiologi ke dalam kurikulum mereka.
Dengan demikian, generasi muda Indonesia dapat lebih siap dalam menghadapi tantangan kesehatan masyarakat dan berkontribusi dalam menciptakan lingkungan yang lebih sehat.
Sumber: Miftahul Mushlih
Penulis: Novia